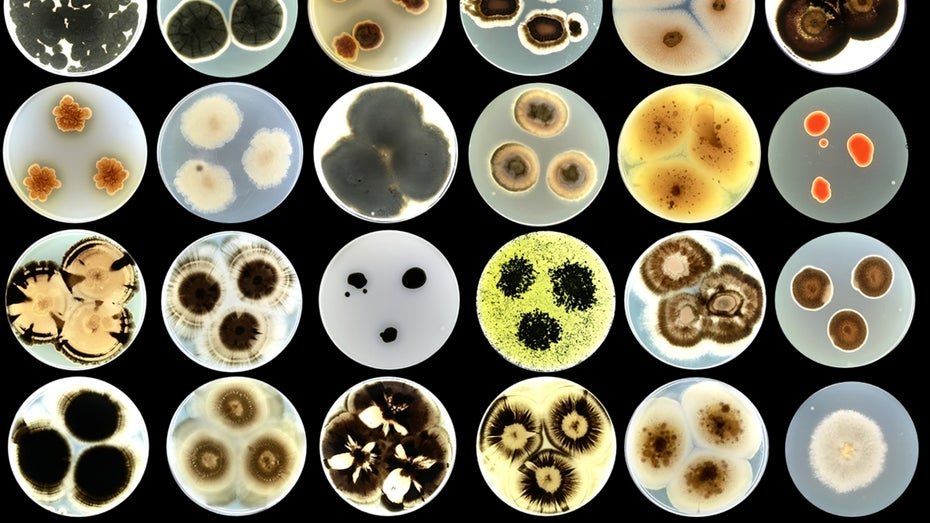
post img

Zölle: Counterpoint halbiert Wachstumsprognose für Smartphone-Markt
Der Smartphone-Weltmarkt dürfte 2025 deutlich langsamer wachsen als ursprünglich angenommen. Schuld sind die neuen US-Zölle.
Read more...
Warner Bros. Discovery: Aufspaltung angekündigt
In einer umfassenden Umstrukturierung trennt der US-Konzern seine Filmstudios samt Streaming vom klassischen Kabelsender-Geschäft.
Read more...
watchOS 26 bringt KI-Fitnesstrainer, neues Design und mehr Komfort
Motivationssprüche direkt ins Ohr – die Apple Watch bekommt mit watchOS 26 neben dem neuen Design einen Fitnesstrainer. Einzelne Funktionen werden komfortabler.
Read more...
Ein Hauch von Mac: Apple verspricht leistungsfähigeres iPadOS 26
Menüleiste, Aktionen im Hintergrund, lokale Audio-Aufzeichnung, Datei-Verwaltung, mehr Freiheit für Fenster.
Read more...
macOS 26 Tahoe: Redesign und neues Versionsschema
Die nächste Version von macOS bekommt ein neues "Liquid Glass"-Design. Zugleich wechselt Apple das System für die OS-Versionen.
Read more...
Top 10: Die beste mechanische Gaming-Tastatur im Test – Keychron ist Testsieger
Mechanische Gaming-Tastaturen sind besonders wegen der Taster, des Aussehens und des Funktionsumfangs beliebt. Wir zeigen die fünf Besten.
Read more...
iOS 26: Glas-Design und neue Funktionen für das iPhone-System
Apple gibt seinen Betriebssystemen einen neuen Anstrich – glasig wie pastellig. Neue Funktionen sind ebenfalls im Anmarsch, auch für Apple Intelligence.
Read more...
Bundesjustizministerin Hubig: Altersgrenze für Social Media ist nötig
Da Social-Media-Plattformen nicht genug für den Jugendschutz tun, spricht sich auch Bundesjustizministerin Hubig für Altersverifikationen und Altersgrenzen aus.
Read more...
Mini-PC für 150 Euro im Test: Ninkear Mbox 11 ist erstaunlich gut
Der Ninkear Mbox 11 kommt im ultrakompakten quadratischen Formfaktor daher und weiß im Test mit seiner geringen Lautstärke auch unter Last zu überzeugen.
Read more...
SwitchBot K20+ Pro: Saugbot mit fahrendem Serviertablett verfügbar
Der Saug- und Wischroboter SwitchBot K20+ Pro putzt nicht nur den Boden, sondern bringt Frühstück ans Bett oder den Ventilator dorthin, wo es heiß ist.
Read more...
ifo-Umfrage: Stellenabbau durch KI erwartet
Nach einer Ifo-Umfrage geht ein Viertel der deutschen Unternehmen von einem KI-bedingten Stellenabbau aus. Besonders betroffen ist wohl die Industrie.
Read more...
GNOME 49 schickt X11 in Rente
Das kommende GNOME 49 läutet das Ende von X11 ein. Es wird Sessions der grafischen Umgebung standardmäßig deaktivieren und in Version 50 komplett entfernen.
Read more...
heise-Angebot: iX-Workshop: IT-Recht für Admins – Wege zur gesetzeskonformen IT-Praxis
CRA, NIS-2 und AI Act: Wie Unternehmen ihre IT rechtssicher betreiben können – praxisorientierte Einblicke aus dem Alltag von Systemadministratoren.
Read more...
heise-Angebot: iX-Workshop: Echtzeitüberwachung mit Prometheus und Grafana
Infrastruktur und Anwendungen effektiv überwachen, Alarme einrichten und Probleme frühzeitig erkennen, um auf kritische Situationen reagieren zu können.
Read more...
heise+ | Switch 2 im Test: Nintendos Antwort auf Steam Deck und PC-Handhelds
Die Switch 2 verspricht Multiplayer-Spaß und Konsolengrafik an jedem Ort. Wir testen, wie sie sich gegen Steam Deck und PC-Handhelds schlägt.
Read more...
Neue Natrium-Brennstoffzelle verspricht Durchbruch für E-Flugzeuge
Forschende am MIT haben eine Natrium-Brennstoffzelle entwickelt, die eine Alternative zu Lithium-Ionen-Akkus und Wasserstoff-Brennstoffzellen darstellen könnte.
Read more...
50 Jahre Videorekorder: Sonys Betamax als erfolgreicher Fehlschlag
1975 brachte Sony die ersten Videorekorder für daheim auf den Markt. Es folgte der große Formatkrieg mit VHS, den Sony nur zum Teil verlor.
Read more...
EU-Datenschützer: Vorsicht bei Informationsersuchen aus Drittstaaten
Die EU-Datenschutzbehörden erläutern, dass Urteile oder Entscheidungen von Behörden aus Drittstaaten wie den USA nicht automatisch anerkannt werden können.
Read more...
Sonne versus Blitz: Click Boom Flash # 39 "Licht in der Fotografie"
"Der Blitz ist in seinem Spektrum dem Tageslicht sehr ähnlich und in meinen Augen die beste fotografische Lichtquelle", sagt Fotograf und Autor Dr. Tilo Gockel.
Read more...
Top 10: Die beste Powerbank im Test – Testsieger kostet 23 Euro
Powerbanks gibt es in allerlei Leistungsklassen: von 10 bis 200 Watt, von 5000 bis 27.000 mAh. Wir haben knapp 30 Modelle aus verschiedenen Preisbereichen getestet und zeigen die zehn besten.
Read more...
Xbox Ally: Asus und Microsoft bauen zwei Windows-Handhelds
Microsoft hat zwei Handhelds mit Xbox-Branding vorgestellt: Beide Modelle kommen mit einer neuen Bedienoberfläche, die sparsamer als Standard-Windows sein soll.
Read more...
Instagram, TikTok und Co erst ab 15 - neue Initiative durch EU-Minister
Mehrere EU-Länder wollen ein Verbot von Social Media für unter 15-Jährige. Die Plattformen seien gefährlich für die Entwicklung der Kinder.
Read more...
Viel Leistung, unverschämt günstig: Mini-PC U58 mit Ryzen 7 für 272 Euro im Test
Gxmo oder Alliwava, egal: Der U58 bietet zum Knüller-Preis von 272 Euro ein starkes Gesamtpaket mit Ryzen 7 & 32 GB RAM. Wo die Stärken und Schwächen des Mini-PCs liegen, zeigt unser Test.
Read more...
Saturn schrumpft: Media Markt übernimmt immer mehr Filialen
In vielen deutschen Städten werden Filialen der Elektronikkette Saturn geschlossen und Media Markt zieht am selben Standort ein. Verschwindet die Marke Saturn?
Read more...
Jensen Huang auf Europatour – auch beim Bundeskanzler
Im Rahmen einer ausgedehnten Europatour plant Huang auch ein Gespräch mit Friedrich Merz. Es dürfte um europäische KI-Rechenzentren gehen.
Read more...
Starlink-Gäste-WLAN im Weißen Haus ohne Sicherheitskontrollen
Im Weißen Haus gibt es strenge Sicherheitsvorkehrungen für Internetnutzer, außer man nutzt Elon Musks Internetdienst Starlink.
Read more...
heise-Angebot: iX-Workshop: API-Design und -Entwicklung mit HTTP, REST und OpenAPI
Lernen Sie, wie man effiziente und benutzerfreundliche APIs entwickelt, HTTP- und REST-Standards anwendet und standardisierte Referenzdokumentationen erstellt.
Read more...
Neue Farbe für Wände: Nachhaltig durch Pilze und Algen?
Eine Tinte aus Pilzen und Algen soll Hauswände vor Schadstoffen schützen, CO₂ speichern und Risse reparieren. Das Projekt will Gebäude nachhaltiger machen.
Read more...
Ton aus dem Display: Schwingende Bildschirme aus Südkorea
Ein Raster aus Piezoelementen mit einem schwingungsdämpfenden Rahmen verwandelt OLED-Panels in Lautsprecher mit räumlichem Klang.
Read more...
Microsoft: Abhilfe für Sicherheitslücke durch gelöschte "inetpub"-Ordner
Windows-Update hat einen "inetpub"-Ordner angelegt. Wird er gelöscht, blockiert das womöglich weitere Updates. Ein Script hilft.
Read more...